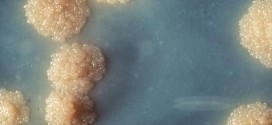
Eine Nahaufnahme einer Mycobacterium tuberculosis-Kultur. Foto: CDC/Dr. George Kubica/Wikimedia Public Domain)

Schleswiger Lehrerin stirbt an Tuberkulose – 120 Schüler und Lehrer werden getestet
SCHLESWIG. Nach dem Tod einer an Tuberkulose erkrankten Lehrerin hat der Kreis Schleswig-Flensburg mit einer sogenannten Umgebungsuntersuchung an der betroffenen Schleswiger Schule begonnen. 120 Schüler und Lehrer würden auf Erreger getestet, sagte die Leiterin des Kreis-Fachdienstes Gesundheit, Jutta Korte. Die Lehrerin war in der vergangenen Woche im Kreis Rendsburg-Eckernförde gestorben. Erst seit Freitag habe es … Schleswiger Lehrerin stirbt an Tuberkulose – 120 Schüler und Lehrer werden getestet weiterlesen
0 Kommentare